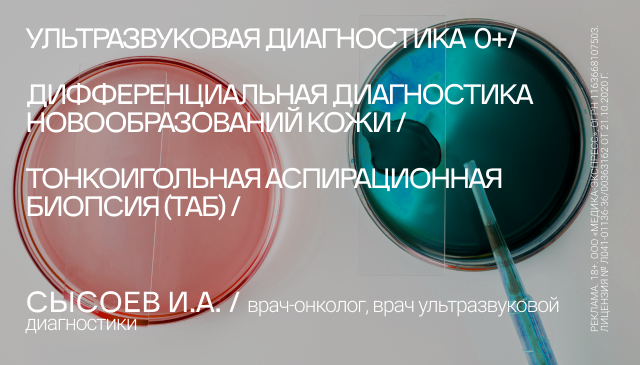
Сысоев в20260331.

СПЕЦИАЛИСТЫ КЛИНИКИ
Шпилёва Ирина Владимировна
Врач-терапевт
Врач ультразвуковой диагностики
Принимает с 16 лет
Самойлов Владимир Сергеевич
Доктор медицинских наук
Врач-хирург
БЕСПЛАТНАЯ КОНСУЛЬТАЦИЯ
Принимает с 18 лет
Генюк Юрий Владимирович
Категория врача: высшая
Принимает с 16 лет
Комолых Наталья Павловна
Врач функциональной диагностики
ЭКГ с 5 лет; ЭКГ с нагрузкой с 18 лет; Консультация с 18 лет; УЗИ сердца с 16 лет; Спирограмма с 12 лет
Духанина Екатерина Сергеевна
Врач ультразвуковой диагностики
Принимает с 18 лет; УЗИ с 0 лет
Сысоев Илья Алексеевич
Принимает с 18 лет; УЗИ с 6 лет; Эхокардиография детям с 0 лет
Отделения и услуги
Почему выбирают нашу клинику?
МНОГОПРОФИЛЬНЫЙМЕДИЦИНСКИЙЦЕНТР
амбулаторноеи стационарноелечение

современнаяхирургия
хирургическиевмешательстваразличной степенисложности

дневной и круглосуточный стационары
1- и 2-местные палатыповышеннойкомфортности, Палатаинтенсивной терапии

Что говорят наши клиенты:Все отзывы
Сегодня в очередной раз посетила Клинику на Чайковского,4а со своим папой 85 лет. Все сотрудники, начиная с охранницы, окружили нас вниманием и заботой. Хочу ... Весь отзыв
Прекрасный доктор,специалист высочайшего класса,очень красивая девушка.
наши контакты
Телефон:
Телефон линии качества обслуживания:
+7 (908) 133-43-22 (с 8:00 до 17:00)
г. Воронеж, ул. Чайковского, 4а
Запишитесь на прием
Запись на приём
Запись на приём
Задать вопрос
Обратный звонок
Оставьте отзыв
Мы всегда рады замечаниям и отзывам!




 +7(473)211-03-03
+7(473)211-03-03